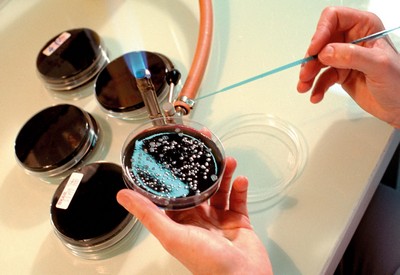

Číslo 11 / 2017
Pacient s legionelovou pneumonií
Legionelóza je bakteriální onemocnění, které obvykle probíhá jako pneumonie s multisystémovým postižením. Onemocnění bylo poprvé popsáno roku 1976, kdy se na shromáždění amerických válečných veteránů (odtud název „legionářská nemoc“) ve Filadelfii v USA infekce rozšířila kontaminovaným aerosolem z klimatizace v hotelu, ve kterém byli účastníci ubytováni, a způsobila epidemii závažných zápalů plic u 221 osob. Celkem 34 účastníků na legionelovou pneumonii zemřelo. Tento článek přináší kazuistiku muže s legionelovou pneumonií.
Původce nemoci odhalili až půl roku po epidemii ve Filadelfii lékaři dr. Charles C. Shepard a dr. Joseph E. McDade a otevřeli tak novou a stále se rozvíjející kapitolu v lidském chápání infekčních onemocnění. Od té doby vědci dokázali retrospektivně vyřešit několik předchozích tajemných epidemií způsobených právě Legionellou.
Retrospektivní výzkumy později zjistily vyskytující se případy legionářské nemoci již v roce 1943.
Etiologie
Legionelóza postihuje převážně starší osoby, jedince s poruchou imunity, kuřáky, chronicky nemocné a silné alkoholiky. Původcem nemoci jsou zástupci rodu Legionella, nejčastěji Legionella pneumophila. Jsou to malé pohyblivé gramnegativní tyčinky, které se běžně vyskytují v přírodních i umělých rezervoárech vody a vodních systémech s teplotou vody 25–45 °C s přítomností některých kovů (železo, zinek a měď). Na jejich odolnosti se podílí schopnost tvořit biofilm. Kromě toho dokáží legionely přečkat nepříznivé období v cystách améb, kde vydrží řadu měsíců plně životaschopné. Nacházejí se v jezerech, řekách a jako zdroj onemocnění byly rozpoznány klimatizační zařízení, vzduchotechnika, vodovodní sítě, sprchy, zvlhčovače, nebulizátory a dekorativní fontány. Vysoká koncentrace legionel bývá převážně ve slepých kovových trubkách a konečných výpustích. Nejméně 20 z přibližně 50 druhů legionel může způsobit onemocnění člověka.
Legionelóza postihuje převážně starší osoby, jedince s poruchou imunity, kuřáky a chronicky nemocné a silné alkoholiky
Přenos onemocnění se děje především vzdušnou cestou, a to inhalací kontaminovaného aerosolu s přítomností legionel. Dokonce byla popsána cesta přenosu pitím nakažené vody, lavážemi žaludku a střev nebo hadicemi u dýchacích přístrojů.
Mortalita u dosud zdravých osob je 15–20 %, u nemocných s oslabenou imunitou nebo pozdě léčených 30–50 %. Přenos z člověka na člověka nebyl prokázán.
Klinický obraz
Jsou známy tři klinické formy průběhu:
1. Asymptomatická forma – zde se prokáže přítomnost Legionella pneumophila mikrobiologickými testy, bez klinických známek infekce.
2. Lehčí forma – pontiacká horečka. Mírnější průběh nemoci připomíná chřipku s benigní horečkou, bolestmi hlavy, kašlem a mírnou zchváceností. Symptomatologie odezní během dvou až pěti dní, bez pneumonie a jiných závažných orgánových postižení.
3. Těžší forma – legionářská nemoc, má inkubační dobu 2–10 dnů. Vyznačuje se těžkou pneumonií, která může vést až k respirační insuficienci. Nemoc převážně začíná horečkou a průjmem. Mezi další příznaky patří myalgie, slabost, cefalea, bolesti na hrudníku a neproduktivní kašel, bolesti hlavy a neurologické projevy (stavy zmatenosti i poruchy vědomí, orientace), poruchy jaterní nebo ledvinové funkce. Během 1–2 dnů se rozvine pneumonie, kdy masivní nález na RTG bývá překvapením. Stav pacienta vyžaduje monitoraci FF a pobyt na JIP.
Léčba
Legionelózu je velmi důležité odlišit od ostatních pneumonií vzhledem k vážné prognóze a důležitosti specifické antibiotické léčby. Legionela je prokazatelná ve sputu metodou PCR, nejvíce užívané je vyšetření průkazu antigenu legionel v moči. Infekci je možné dodatečně potvrdit i sérologicky. Antibiotika první volby jsou makrolidy (klarithromycin, azithromycin) nebo fluorochinolony (ofloxacin, ciprofloxacin), popřípadě v kombinaci s rifampicinem. Doba terapie činí většinou 14 dní. Úplné vymizení RTG plicních nálezů trvá i několik měsíců.
Prevence
Protože v současné době není k dispozici humánní vakcína, můžeme riziko vzniku legionářské nemoci snížit udržováním dobré tělesné kondice – sport, dostatečný spánek, pravidelná a zdravá strava a omezení působení stresu.
Prevence legionelózy se rovněž zaměřuje na technické úpravy a čištění zařízení produkujících aerosol a také na dezinfekci v nich cirkulující vody. Jako nejúčinnější metoda se jeví krátkodobé zahřátí na 80 °C. Chlór na likvidaci legionel nemá vliv. Důležitý je dobře fungující systém kontroly údržby vodovodního systému, tzn. monitorování vodovodních systémů za provozu, odběr vzorků vody, čištění a dezinfekce systémů.



Výsledek pozitivního průkazu antigenu Legionella pneumophila v moči
Kazuistika
Dne 1. listopadu 2016 byl na standardní oddělení Kliniky infekčních chorob (KICH) Fakultní nemocnice Brno (FN Brno) přijat 73letý pacient K. Ř. pro febrilní stav nejasné etiologie.
Při vstupním vyšetření byl pacient lucidní, orientovaný místem, časem i osobou, spolupracující. Pacient byl febrilní, ležící, ale posadil se s pomocí, byl slabý, ameningeální, měl mírný tremor HKK, uváděl pouze pocit ucpaného nosu a bolesti zad, které postupně progredovaly. Horečku 39–40 °C měl již 4. den. Ze začátku chodil častěji močit, nyní močí méně. Jeho stav se postupně zhoršoval, byl velmi zesláblý, den před příjmem doma zkolaboval, ale lékaře nevyhledal. V den příjmu se bolesti bederní páteře zhoršily, začínal být apatický, proto jeho manželka zavolala rychlou zdravotnickou pomoc (RZP). Pacient K. Ř. byl vyšetřen a přijat na standardní oddělení s diagnózou infekce močového ústrojí neurčené lokalizace (N 390).
Při vstupním vyšetření
RA: bezvýznamná.
OA: arteriální hypertenze, hyperlipidémie, DM II. typu na PAD.
FA: trvale sine.
Alergie: neudává.
FF: močení bez dysurií, stolice normální konzistence, bez příměsí, chuť k jídlu asi měsíc špatná, zhubnul, neví kolik, tři dny nejedl.
Abusus: kuřák – 30 cigaret denně od svých 20 let, alkohol příležitostně.
PSA: starobní důchodce, dříve psycholog, bydlí s manželkou v rodinném domě.
EA: nikdo v okolí nemocný nebyl, ATB v poslední době neužíval, nadstandardní očkování nemá, opary nemívá, klíště neměl, v přírodě je často.
1.–3. listopadu 2016
Před přijetím na standardní oddělení KICH byl vyšetřen na Nízkoprahovém urgentním příjmu (NUP) FN Brno, kde mu byl proveden RTG plic i UZ břicha – negativní, laboratorně elevace zánětlivých parametrů. Empiricky mu na KICH byla nasazena terapie Cefotaximem i. v. V den přijetí byla také provedena MR LS páteře a vzhledem k počínající zmatenosti 2. 11. 2016 LP – obojí s negativním nálezem. Kontrolní odběry byly s progresí zánětlivých parametrů, kultivace moči negativní, hemokultury, moč K+C a výtěr z krku byly odebrány. K vyloučení fokusu bylo objednáno ECHO srdce. V plánu bylo též akutní CT mozku – pacient je encefalopatický. Bylo provedeno OPG, RTG PND, dále byl pacient vyšetřen zubním a ORL lékařem. Pacient byl laboratorně sledován, byly mu měřeny FF, podáván O2, léky dle ordinace lékaře a probíhala celková ošetřovatelská péče o pacienta.
4. listopadu 2016
Byla hlášena pozitivita legionelového antigenu v moči a vzhledem k septickému stavu s encefalopatií při čerstvě prokázané legionelové infekci byl pacient přeložen k monitoraci na JIP KICH pro riziko multiorgánového selhání.
Pacient je při vědomí, orientován však pouze osobou, usmívá se, potíže popírá, odpovědi jsou však zmatené, místy zcela nepřiléhavé, řeč huhňavá, jednoduché výzvě vyhoví, má lehkou klidovou dušnost, třes a mírný motorický neklid.
Na JIP byl pacientovi zajištěn centrální žilní katetr, byl zacévkován, O2 aplikován maskou. Také bylo natočeno EKG a následovalo vyšetření RTG P+S po kanylaci centrální žíly. Vzhledem k encefalopatii byla zahájena kombinovaná léčba ATB – Klarithromycin parenterálně + Benemicin per os.
Pacient ihned po vyšetření somatického stavu odjíždí na akutní CT mozku, kde je popsána v. s. hypoxicko-ischemická leukoencefalopatie.
Laboratorně je nadále sledován, jsou mu měřeny FF, podávány léky dle ordinace lékaře a pokračuje celková ošetřovatelská péče o pacienta na JIP.
Syn byl o závažnosti stavu a přesunu pacienta na JIP telefonicky informován ošetřující lékařkou.
5.–10. listopadu 2016
Pacient je laboratorně sledován. Jsou mu měřeny FF, podávány léky dle ordinace lékaře. Podáván O2 a celková ošetřovatelská péče o pacienta na JIP je zajištěna. Probíhá rehabilitace a rodina je průběžně informována o zdravotním stavu pacienta.
11. listopadu 2016
Klinický stav pacienta se již výrazně zlepšil, současně dochází k poklesu zánětlivých parametrů. Pacient je vertikalizován do stoje u lůžka, již 3. den je afebrilní. Dýchání vlevo je bazálně ještě oslabené, ale pacient je plně orientovaný. Předchozí den mu byl extrahován PMK. Pacient je přeložen na standardní oddělení.
12.–16. listopadu 2016
Pokračování v ATB léčbě, pacientovi jsou podávány léky dle ordinace lékaře, probíhá celková ošetřovatelská péče o pacienta a rehabilitace.
17. listopadu 2016
Pacient je propuštěn do domácího ošetřování.
Doporučení:
Kontrola TK, P, EKG u PL. Vhodné sledování v interní ambulanci. Kontrola v ambulanci pro komplikované plicní záněty s RTG plic + levý boční snímek.
Odběry:
Biochemie: krev – glykémie opakovaně, urea, kreatinin, Na, K, Cl, Ca, P, Mg, Bili, ALT, AST, GGT, ALP, CRP, AMS, LD, ABR, laktát, likvor – biochemie, laktát + cytologie, moč – M+S
Hematologie: KO + diff., INR, aPTT, fibrinogen, DD.
Mikrobiologie: krev – hemokultura z periferie 3krát, moč – K+C, Ag pneumokok + legionella, sputum – legionella.
Krevní banka: krevní skupina.
Léky:
Intravenózní podání – Cefotaxime 8 g/24 hodin, Klacid 500 mg 2×D, Paracetamol Kabi 1 g, Furosemid 20 mg, Metronidazol 500 mg.
Subkutánní podání – Fraxiparine 0,4 ml, Fraxiparine 0,6 ml.
Intramuskulární podání: Almiral 75 mg.
Perorální podání – Benemicin 300 mg 2krát denně, Prokanazol 100 mg jednou denně, Klacid 500 mg 2krát denně, Agen 10 mg, Betamed 20 mg, Tiapridal 100 mg, Furon 40 mg, Mg lactici 500 mg, Ambrobene sol., Rivotril 0,5 mg.
Infuze:
Fyziologický roztok 1/1 100 ml, 250 ml a 500 ml, Ringerfundin 1000 ml, NaH2PO4 100 ml, KCl 7,5 %.
Zobrazovací metody a ambulantní vyšetření:
EKG, RTG P+S, OPG, RTG PND, UZ břicha, MR bederní páteře, TTE srdce, CT mozku, oční konzilium před LP, ORL konzilium, zubní konzilium.



Diagnostický set k vyšetření průkazu antigenu legionel v moči Alere BinaxNOW®
fota: Profimedia, OKM FN Brno, RTG FN Brno, autorka
AKTUÁLNÍ SESTERSKÉ DIAGNÓZY
00007 Hypertermie v souvislosti s infekčním onemocněním, projevujícím se zvýšenou tělesnou teplotou, zvýšenou dechovou frekvencí, zrychleným srdečním pulsem a teplou pokožkou na dotek.
00027 Deficit tělesných tekutin v souvislosti se sníženým příjmem tekutin, projevující se poklesem diurézy a slabostí.
00032 Neefektivní dýchání v souvislosti s hypertermií, projevující se pocitem dušení.
00093 Únava v souvislosti s pocitem vyčerpanosti z infekčního onemocnění, projevující se zvýšenou slabostí a sníženou fyzickou výkonností.
00096 Nedostatek spánku v souvislosti s pocitem nedostatečného odpočinku, projevující se zavíráním očí během rozhovoru.
00002 Nevyvážená výživa – menší příjem jako tělesná potřeba v souvislosti s nezájmem o jídlo, projevující se nechutenstvím a malým příjmem potravy.
00126 Deficit vědomostí v souvislosti hospitalizací, projevující se neznalostí informací o svém zdravotním stavu.
00132 Akutní bolest bederní páteře a celého těla v souvislosti s infekčním onemocněním, projevující se zchváceností celého těla.
00108 Deficit sebepéče při hygieně v souvislosti s celkovou únavou, projevující se neschopností umýt si jednotlivé části těla a osušit se.
00102 Deficit sebepéče při stravování v souvislosti s celkovou únavou, projevující se neschopností přijímat dostatek jídla a pití.
00109 Deficit sebepéče při oblékání v souvislosti s celkovou únavou, projevující se zhoršenou schopností obléknout a svléknout si části oděvu.
POTENCIÁLNÍ SESTERSKÉ DIAGNÓZY
00028 Riziko deficitu tělesných tekutin v souvislosti s nadměrným pocením.
00004 Riziko infekce v souvislosti se zavedením periferní kanyly.
00004 Riziko infekce v souvislosti se zavedením centrální žíly do v. subclavia l. dx.
00004 Riziko infekce v souvislosti se zavedením permanentního močového katetru.
00047 Riziko porušení kožní integrity v souvislosti se zvýšenou tělesnou teplotou.
00155 Riziko pádu v souvislosti s akutním onemocněním.
Mgr. Bronislava Babáčková, Klinika infekčních chorob, FN Brno
Literatura:
1. Chorobopis pacienta K. Ř. psaný MUDr. Michaelou Freibergerovou
2. Rozsypal H, Holub M, Kosáková M. Infekční nemoci ve standardní a intenzivní péči. Praha: Univerzita Karlova v Praze, 2013. ISBN 978-80-246-2197-5
3. Beneš J. Infekční lékařství. Praha: Galén, 2009. ISBN 978-80-7262-644-1
4. Povová J, Zlámalová R, Hozák A, Martinková I, Matějková M, Janout V. Epidemiologie a rizikové faktory u legionelózy. Epidemiologie, mikrobiologie, imunologie. 2014;63(4):285–288. ISSN 1210-7913
5. Matuška P, Drašar V, Sventeková Š, Pilařová O, Skříčková J, Zimová I. Legionelová pneumonie – kazuistika = Legionella pneumonia. Studia pneumologica et phtiseologica. 2004;64(2):68–72. ISSN 0371-2222
6. Hobzová M, Kolek V. Nezapomínáme v diagnostice a léčbě pneumonií na legionelové pneumonie? Nozokomiálne nákazy. 2007;6(3):19–29. ISSN 1336-3859
7. Chalupa P. Legionelóza se šíří hlavně vzdušnou cestou. Zdravotnické noviny – Příl. 2000;49(35). ISSN 0044-1996
8. Metodický návod k zajištění programu surveillance legionelóz. Věstník Ministerstva zdravotnictví České republiky. 2000;(1):2–7. ISSN 1211-0868
Další články v tomto čísle
- Život je krátký a svět velký (neznámý autor)
- Duševní onemocnění? Bojujete s předsudky a neporozuměním
- Bezpečné podávání léků, které navíc šetří peníze? V ÚVN vědí, jak na to
- Bez soli to nejde, ale potřebujeme jí tolik?
- Zdravotní rizika cestování dětí do ciziny
- Péče o pacientku s amébovým jaterním abscesem a specifika práce na Klinice infekčních nemocí 1. LF UK a ÚVN
- Zkušenosti s ambulantním podáváním i. v. antibiotik ve Stacionáři pro parenterální antibiotickou léčbu na Klinice infekčních nemocí 1. LF UK a ÚVN
- Nezvyčajná zoonóza – kazuistika
- Early Warning Score v praxi
- Ošetřovatelská péče a novinky v péči o periferně inzerované centrální katetry











